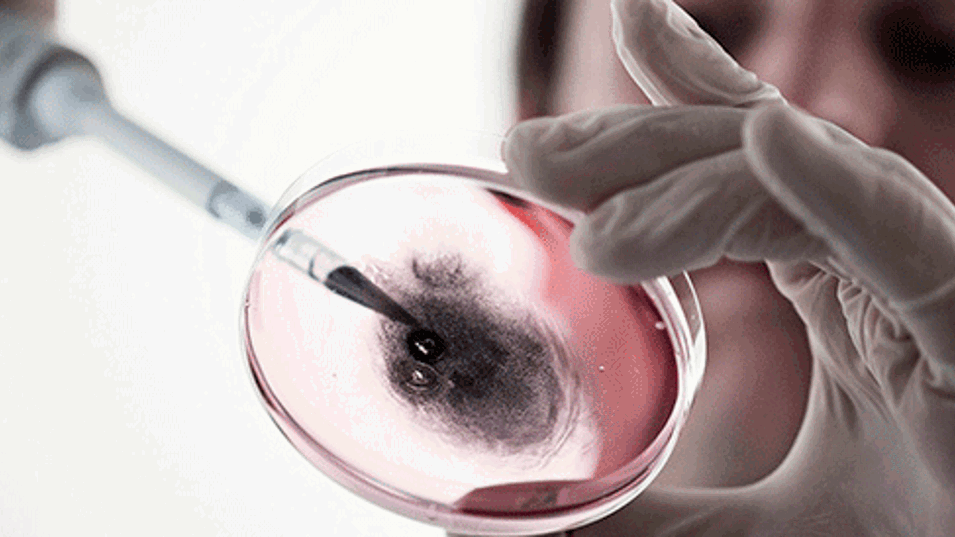

Langvarig inflammation efter udsættelse for carbon black nanopartikler
Det Nationale Forskningscenter for Arbejdsmiljø - Af: Kirsten Rydahl - 14-12-2015
Carbon black nanopartikler udløser en langvarig reaktion i lungerne på mus. Udsættelse for en dosis, der svarer til ni arbejdsdage ved den danske grænseværdi, udløste inflammation og akutfase respons, som varede i mindst 42 dage.
Carbon black nanopartikler udløser inflammation, hvis de kommer ned i lungerne, men det er uklart, hvordan det biologiske respons udvikler sig over tid. Danske og canadiske forskere har derfor undersøgt, hvordan carbon black nanopartikler påvirker mus i op til 42 dage efter, at musene har fået partiklerne ned i lungerne. Resultaterne tyder på, at inflammationen kan være kronisk.
Undersøgt effekt efter 42 dage
Mus blev udsat for samme mængde af partiker, man er udsat for, hvis man arbejder otte timer om dagen i ni arbejdsdage ved koncentrationer i luften, der svarer til de gældende danske grænseværdier for arbejdsmiljøet. Forskerne målte reaktionen i musenes lunger 8 gange i perioden fra 3 timer og op til 42 dage efter, at musene blev udsat for partiklerne.
Flere ændringer i genernes udtryk undervejs
Resultaterne viser blandt andet, at den måde, generne i musenes lunger kom til udtryk på, ændrede sig flere gange i løbet af de 42 dage. Ændringerne blev registreret første gang tre timer efter, at musene fik nanopartiklerne ned i lungerne. Fire dage efter var det genetiske udtryk i lungerne normalt for så at ændre sig igen 14 og 42 dage efter påvirkningen. Der blev ikke foretaget målinger mellem dag 14 og 42 eller senere end 42 dage.
Forskellige gener udtrykt over tid
Gennem hele perioden blev der generelt skruet op for aktiviteten i de gener, der styrer tre biologiske processer:
- immunforsvar
- bekæmpelse af inflammation
- sårheling.
Aktiviteten steg også i en række gener på specifikke tidspunkter i perioden. Det gælder fx gener, der reagerer på kemisk eller fysisk stress i kroppen (oxidativ stress) og gener, der regulerer programmeret celledød (apoptose), hvor cellerne dør spontant uden påvirkning udefra.
Glidebane mod kronisk inflammation?
Lungernes første reaktion på partiklerne er et akut inflammatorisk respons hurtigt efterfulgt af bl.a. oxidativt stress og DNA strengbrud.
- Denne undersøgelse viser, at en dosis carbon black nanopartikler, som svarer til, hvad medarbejdere på danske arbejdspladser må udsættes for i løbet af ni arbejdsdage, forårsager meget langvarig inflammation og akutfaserespons hos mus, forklarer Ulla Vogel, professor og leder af Dansk Center for Nanosikkerhed på Det Nationale Forskningscenter for arbejdsmiljø (NFA).
Den langvarige inflammation og akutfaserespons kan kædes sammen med øget risiko for hjertekarsygdom, fordi akutfaserespons i sig selv øger risikoen for hjertekarsygdom.
Andre resultater fra undersøgelsen
Resultaterne fra undersøgelsen viser også, at
- musene havde inflammation i lungerne gennem hele perioden. Det bliver målt som antallet af inflammatoriske celler i lungevæske fra musene (neutrofilt influx), og forskerne så den største stigning i neutrofilt influx 1 dag efter, at musene fik carbon black nanopartikler ned i lungerne.
- der var carbon black nanopartikler til stede i makrofagerne i lungevæsken fra mus selv efter 42 dage.
- der var et forøget antal DNA strengbrud i celler i lungevæsken tre timer efter påvirkningen med nanopartikler og i væv fra lungerne 2-5 dage efter udsættelse.
Kort om carbon black
Læs den videnskabelige artikel
Yderligere oplysninger